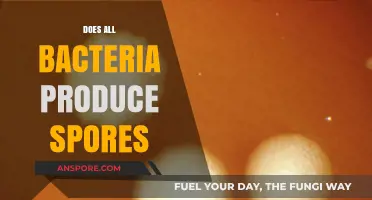
Do All Bacteria Form Spores? Unraveling Microbial Survival Strategies

Antheridium, a male reproductive structure found in plants and certain algae, plays a crucial role in sexual reproduction by producing sperm cells. However, when considering whether antheridia produce spores, it’s important to distinguish between their function and that of sporangia, which are responsible for spore formation. Antheridia are specifically involved in gamete production, while spores are typically generated by structures like sporangia in the life cycles of plants and algae. Therefore, antheridia do not produce spores; instead, they focus on generating male gametes essential for fertilization.
Explore related products
What You'll Learn
- Antheridium Structure and Function: Antheridia produce sperm, not spores, in bryophytes and ferns
- Spores vs. Gametes: Spores are reproductive cells; antheridia produce gametes, not spores
- Bryophyte Reproduction: Antheridia in mosses and liverworts release sperm, not spores
- Fern Life Cycle: Ferns have separate spore and gametophyte stages; antheridia produce sperm
- Misconceptions Clarified: Antheridia do not produce spores; they produce male gametes for fertilization

Antheridium Structure and Function: Antheridia produce sperm, not spores, in bryophytes and ferns
Antheridia, often misunderstood in their role within plant reproduction, are specialized structures found in bryophytes (like mosses and liverworts) and ferns. Unlike what some might assume, antheridia do not produce spores; their primary function is to generate sperm cells. This distinction is crucial for understanding the reproductive strategies of non-seed plants. While spores are haploid cells designed for dispersal and growth into gametophytes, sperm are male gametes that fertilize egg cells, leading to the formation of a diploid zygote. This clarification highlights the unique role of antheridia in sexual reproduction, setting them apart from sporangia, which produce spores.
To visualize the structure of an antheridium, imagine a small, sac-like organ typically located on the gametophyte of the plant. Inside, sperm cells develop through a process called spermatogenesis. These sperm are flagellated, meaning they possess whip-like structures that allow them to swim through a film of water to reach the archegonium, where the egg is housed. This dependence on water for fertilization underscores the evolutionary adaptation of bryophytes and ferns to moist environments. For gardeners or botanists cultivating these plants, maintaining adequate moisture is essential to facilitate successful reproduction.
Comparing antheridia to other reproductive structures reveals their specialized function. In contrast to sporangia, which produce spores for asexual reproduction and dispersal, antheridia are exclusively involved in sexual reproduction. This division of labor ensures genetic diversity, a key advantage in evolving plant species. For instance, in mosses, the gametophyte generation dominates the lifecycle, and antheridia play a pivotal role in perpetuating the species. Understanding this distinction can help educators and students alike grasp the complexities of plant lifecycles more effectively.
Practical applications of this knowledge extend to conservation efforts and horticulture. Bryophytes and ferns are often indicators of ecosystem health, particularly in terms of moisture and air quality. By recognizing the role of antheridia in their reproduction, conservationists can design habitats that support these plants’ lifecycle requirements. For hobbyists growing ferns or mosses indoors, replicating their natural environment—including consistent humidity and indirect light—can enhance their reproductive success. This approach not only fosters healthier plants but also contributes to the preservation of biodiversity.
In summary, antheridia are not spore-producing structures but are vital for sexual reproduction in bryophytes and ferns. Their function in generating sperm cells underscores the intricate balance of plant lifecycles and their adaptation to specific environments. Whether for academic study, conservation, or horticulture, understanding antheridia’s role provides valuable insights into the reproductive strategies of non-seed plants. This knowledge encourages a deeper appreciation for the diversity and complexity of plant life.
Saryn's Spores and Viral Damage: Maximizing Warframe's Toxic Synergy
You may want to see also

Spores vs. Gametes: Spores are reproductive cells; antheridia produce gametes, not spores
In the intricate world of plant and fungal reproduction, understanding the distinction between spores and gametes is crucial. While both are reproductive cells, their roles and origins differ significantly. Spores are typically produced by plants, fungi, and some protozoa as part of their life cycle, often serving as a means of dispersal and survival in harsh conditions. Gametes, on the other hand, are sex cells—sperm and eggs—that fuse during fertilization to form a new organism. Antheridia, structures found in certain plants and algae, are specifically responsible for producing male gametes, not spores. This fundamental difference highlights the specialized functions of reproductive cells in various organisms.
Consider the life cycle of a fern as an illustrative example. Ferns produce spores in structures called sporangia, which are located on the underside of their fronds. These spores germinate into a small, heart-shaped gametophyte, which then develops antheridia and archegonia. The antheridia produce sperm, while the archegonia house the eggs. When sperm from the antheridia fertilizes an egg in the archegonium, a new fern plant begins to grow. Here, the antheridia’s role is clear: they produce gametes, not spores. This example underscores the importance of distinguishing between these reproductive cells in biological processes.
From a practical standpoint, understanding this distinction is vital for fields like botany, mycology, and agriculture. For instance, in cultivating spore-producing plants like ferns or mushrooms, knowing that antheridia do not contribute to spore production helps focus efforts on the correct structures—sporangia or similar organs. Conversely, in studying fertilization processes in algae or bryophytes, recognizing that antheridia produce sperm ensures accurate identification and manipulation of gametes. Misidentifying these structures or their functions could lead to inefficiencies in research, conservation, or cultivation practices.
A persuasive argument can be made for the educational value of this distinction. Teaching students about the specific roles of spores and gametes, and the structures that produce them, fosters a deeper appreciation for the complexity of life cycles. For example, in a high school biology class, demonstrating the difference between an antheridium and a sporangium using models or live specimens can clarify abstract concepts. This knowledge not only enhances academic understanding but also lays the groundwork for careers in biology, ecology, and related fields.
In conclusion, while spores and gametes are both reproductive cells, their functions and origins are distinct. Antheridia, as producers of male gametes, play a specific role in sexual reproduction, whereas spores are involved in asexual reproduction and dispersal. Recognizing this difference is essential for both theoretical understanding and practical applications in biology and related disciplines. By focusing on these specifics, we gain a clearer, more nuanced view of the reproductive strategies employed by diverse organisms.
Indian Pipes: Do They Produce Seeds or Spores?
You may want to see also

Bryophyte Reproduction: Antheridia in mosses and liverworts release sperm, not spores
A common misconception in botany is that antheridia produce spores. In reality, antheridia in bryophytes—mosses, liverworts, and hornworts—function as male sex organs that release sperm, not spores. This distinction is crucial for understanding the reproductive biology of these non-vascular plants. While spores are asexual reproductive units produced in sporangia, sperm are motile gametes that require water to swim to the female archegonia for fertilization. This process highlights the sexual reproduction cycle of bryophytes, contrasting with the asexual spore dispersal seen in ferns and other spore-producing plants.
To visualize this, consider the life cycle of a moss. After the antheridia mature, they release flagellated sperm into a water film, which then swim to nearby archegonia. Fertilization results in the formation of a diploid sporophyte, which eventually produces spores via meiosis. These spores germinate into haploid gametophytes, restarting the cycle. The role of antheridia in this process is strictly to produce sperm, not spores, making them a key player in the sexual phase of bryophyte reproduction.
From a practical standpoint, understanding this distinction is essential for horticulture and conservation efforts. For instance, when cultivating mosses in a garden, ensuring a water source is critical for sperm mobility during the reproductive phase. Without water, fertilization cannot occur, and the moss will fail to complete its life cycle. Similarly, in laboratory settings, researchers studying bryophyte genetics must replicate these moist conditions to observe sexual reproduction accurately.
Comparatively, this reproductive strategy sets bryophytes apart from other plant groups. While ferns and lycophytes produce spores directly from sporangia, bryophytes rely on a more complex sexual process involving antheridia and archegonia. This difference underscores the evolutionary significance of bryophytes as a bridge between algae and more advanced land plants. Their reliance on water for reproduction also explains their preference for damp, shaded habitats.
In conclusion, antheridia in mosses and liverworts are not spore producers but sperm factories, integral to their sexual reproduction. This fact not only clarifies a common botanical misunderstanding but also emphasizes the unique adaptations of bryophytes. Whether for academic study, conservation, or gardening, recognizing this distinction is key to appreciating the intricate life cycle of these ancient plants.
Where to Find Galactic Outfitter Spore: A Comprehensive Guide
You may want to see also
Explore related products

Fern Life Cycle: Ferns have separate spore and gametophyte stages; antheridia produce sperm
Ferns, unlike many plants, have a life cycle that alternates between two distinct stages: the spore-producing sporophyte and the gamete-producing gametophyte. This alternation of generations is a hallmark of their reproductive strategy. The antheridia, a critical component of this cycle, are structures found on the gametophyte that produce sperm. This process underscores the complexity and elegance of fern reproduction, which has remained largely unchanged for millions of years.
To understand the role of antheridia, consider the fern life cycle as a relay race. The sporophyte generation, the fern we typically recognize, produces spores via structures called sporangia. These spores are not seeds but single-celled entities that disperse and germinate into the gametophyte generation, a small, heart-shaped plant. The gametophyte is bisexual, meaning it contains both antheridia (sperm-producing organs) and archegonia (egg-producing organs). When conditions are moist, sperm from the antheridia swim to the archegonia to fertilize the egg, initiating the growth of a new sporophyte. This separation of generations ensures genetic diversity and adaptability.
From a practical standpoint, observing this cycle can be both educational and rewarding. To witness antheridia in action, collect fern spores from the underside of mature fronds and sow them on a moist, sterile medium like potting soil or agar. Keep the environment humid and warm, around 70°F (21°C), to encourage gametophyte growth. Within weeks, you’ll see tiny, green gametophytes develop. Under a magnifying glass or microscope, you can identify the antheridia as small, rounded structures. For best results, maintain consistent moisture, as dryness can halt development. This hands-on approach not only deepens understanding but also highlights the intricate interplay between structure and function in fern reproduction.
Comparatively, ferns’ reproductive strategy contrasts sharply with that of flowering plants, which rely on seeds and pollen. While seeds are multicellular and nutrient-rich, fern spores are minimalistic, requiring specific conditions to thrive. The antheridia’s role in producing motile sperm further distinguishes ferns, as this requires water—a limitation that confines fertilization to moist environments. This dependency on water explains why ferns are often found in humid habitats like forests and riverbanks. By studying these differences, we gain insight into how plants have evolved diverse reproductive mechanisms to survive in varying ecosystems.
In conclusion, the antheridia’s function in fern reproduction is a fascinating example of nature’s ingenuity. By producing sperm that fertilize eggs on the same gametophyte or nearby ones, ferns ensure continuity while maintaining genetic diversity. This process, though dependent on specific conditions, showcases the resilience and adaptability of these ancient plants. Whether you’re a botanist, educator, or hobbyist, exploring the fern life cycle offers a window into the intricate world of plant reproduction, where even the smallest structures play monumental roles.
Mushroom Spores and Allergies: Uncovering the Hidden Triggers and Symptoms
You may want to see also

Misconceptions Clarified: Antheridia do not produce spores; they produce male gametes for fertilization
A common misconception in botany and mycology is that antheridia produce spores. This confusion likely arises from the structural similarities between antheridia and sporangia, both being involved in reproductive processes. However, their functions are fundamentally different. Antheridia are specialized structures found in certain plants, fungi, and algae, and their primary role is to produce male gametes, not spores. Understanding this distinction is crucial for accurately describing reproductive mechanisms in these organisms.
To clarify, let’s break down the process. In organisms like bryophytes (mosses, liverworts, and hornworts), antheridia develop on the gametophyte generation. Within these structures, male gametes, or sperm, are produced through mitosis. These sperm are then released and must swim through a water medium to reach the archegonia, where female gametes (eggs) are housed. Fertilization occurs, leading to the formation of a sporophyte, which eventually produces spores. The key takeaway here is that antheridia are involved in the sexual reproduction phase, not in spore production, which occurs in a separate structure called the sporangium.
From a practical standpoint, this clarification is essential for educators, students, and researchers. For instance, in a biology classroom, teaching the correct function of antheridia prevents students from conflating sexual reproduction with asexual spore dispersal. Similarly, in botanical research, accurate terminology ensures that studies on reproductive strategies are not misinterpreted. A simple mnemonic to remember: antheridia are for "antherozoids" (sperm), not spores. This distinction also highlights the complexity of life cycles in plants and fungi, where different structures serve distinct roles in alternating generations.
Comparatively, the confusion might stem from the broader role of spores in plant and fungal life cycles. Spores are typically associated with dispersal and survival, produced by sporophytes in plants or sporangia in fungi. In contrast, antheridia are transient structures focused solely on gamete production. For example, in ferns, spores grow into gametophytes, which then develop antheridia and archegonia. The antheridia’s role ends with fertilization, while spores represent the next generation’s starting point. Recognizing this difference underscores the precision required in biological terminology.
Finally, addressing this misconception has broader implications for understanding biodiversity. Many non-vascular plants and algae rely on antheridia for reproduction, and misidentifying their function could lead to oversimplified models of their life cycles. For hobbyists cultivating mosses or liverworts, knowing that antheridia produce sperm, not spores, can guide proper care and propagation techniques. In essence, while antheridia and spores are both critical to reproductive strategies, their roles are distinct, and clarity on this point enriches both scientific discourse and practical applications.
Can Spores Transform into Fungi? Unveiling the Growth Process
You may want to see also
Frequently asked questions
No, antheridium does not produce spores. It is a male reproductive organ in certain plants and algae that produces sperm cells, not spores.
The antheridium’s role is to produce and release sperm cells, which then fertilize the egg cells in the female reproductive organ (archegonium) to form a zygote.
Yes, spores are involved in the life cycle of organisms like ferns and mosses, but they are produced by sporangia, not antheridia. Antheridia are specifically for sexual reproduction.